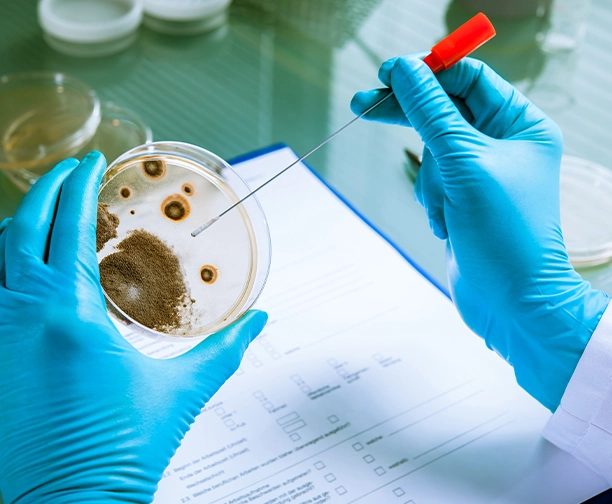
OPEN-MINDEDNESS

Wir glauben, dass Innovation nicht an die Geografie gebunden sein sollte.


Seit 2018 ist Omics Empower ein vertrauens würdiger Partner für Einzelzellen-und räumliche Transkript omik und unterstützt Forscher mit fortschritt lichen Multi-Omics-Diensten. Mit unserem One-Stop-Modell können sich Wissenschaftler von der Proben vorbereitung bis zur Bio informatik auf ihre Forschung konzentrieren, während wir uns um den Rest kümmern.
Unsere erfahrenenPhD-TeamIst hier, um Ihr Projekt mit vertrauens würdiger technischer Expertise zu unterstützen-geleitet von den gleichen Standards der Zuverlässigkeit, auf die sich Wissenschaftler jeden Tag verlassen.

Aded für aktives Zuhören und offenen Dialog, unterschied liche Perspektiven ohne starre Bindung an persönliche Standpunkte.
Engagiert sich für kontinuierliches Lernen und Selbst verbesserung, um die Falle der Selbst zufriedenheit zu vermeiden.
Engagiert sich für kontinuierliches Lernen und Selbst verbesserung, um die Falle der Selbst zufriedenheit zu vermeiden.

Sich mit Entschlossenheit Hindernissen stellen und sie als Wachstums chancen nutzen.
Streben Sie täglich nach Fortschritten, um besser zu werden als gestern.
Hohe Standards setzen: Halten Sie sich auf höchstem Niveau von Leistung und Qualität.

Standfest bei der Einhaltung ethischer Grundsätze und bietet eine verlässliche Grundlage für alle Handlungen.
Mutig darin, Rechenschaft pflicht anzunehmen und sicher zustellen, dass Verantwortung mit Mut und Überzeugung erfüllt wird.

Geht mit akribischer Liebe zum Detail an Aufgaben heran, verzichtet bei allen Bestrebungen auf Nachlässigkeit.
In der Realität begründet, um sicher zustellen, dass Handlungen und Entscheidungen auf überprüfbaren Fakten und echten Erkenntnissen beruhen.
Singapur Globaler Hauptsitz:112 ROBINSON ROAD #03-01
Germany: Arnold-Graffi-Haus / D85 Robert-Rössle-Straße 10 13125 Berlin
Vereinigte Staaten:2 Goddard, Irvine, CA 92618, Vereinigte Staaten
Hong Kong:Wohnung 1019B, 10/F, Liven House, Nr. 61-63 King Yip Street, Kwun Tong
Singapur Globaler Hauptsitz:112 ROBINSON ROAD #03-01
Germany: Arnold-Graffi-Haus / D85 Robert-Rössle-Straße 10 13125 Berlin
Vereinigte Staaten:2 Goddard, Irvine, CA 92618, Vereinigte Staaten
Hong Kong:Wohnung 1019B, 10/F, Liven House, Nr. 61-63 King Yip Street, Kwun Tong